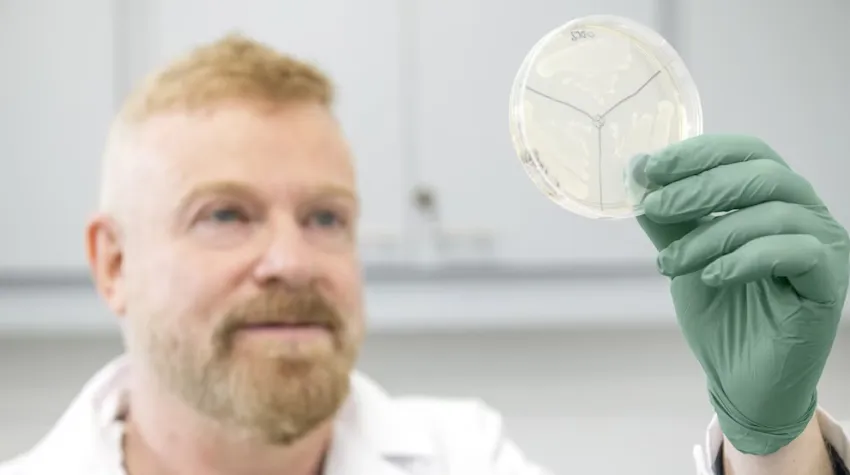

Gabriel Rabinovich, bioquímico, doctor en Inmunología e investigador, dedicó más de tres décadas a desentrañar los complejos mecanismos del cáncer desde Argentina. Su investigación se centra en el papel crucial de una proteína, la galectina-1 (GAL1), tanto en enfermedades oncológicas como autoinmunes. Recientemente, su equipo logró un nuevo hito al identificar un circuito molecular inédito que permite a los tumores evadir el sistema inmune y generar nuevos vasos sanguíneos para crecer, un avance publicado en la prestigiosa revista Immunity.
El corazón de este nuevo descubrimiento radica en cómo la galectina-1 interactúa con azúcares (glicanos) y regula la actividad de las células mieloides supresoras (MDSCs). Estas MDSCs, producidas en la médula ósea, tienen la capacidad de bloquear la respuesta inmunitaria y facilitar la expansión del cáncer. Rabinovich explicó que estos resultados aportan “nuevas perspectivas terapéuticas para el futuro tratamiento del cáncer”, conectando directamente los programas inmunitarios y vasculares que impulsan el crecimiento tumoral.
Los investigadores no solo identificaron este circuito, sino que también demostraron que una alta expresión de GAL1 se asocia con un peor pronóstico en pacientes. Lo más prometedor es que al bloquear este mecanismo con un anticuerpo neutralizante, se logró reducir el crecimiento tumoral en ratones. Este hallazgo abre la puerta a mejorar la eficacia de tratamientos actuales como la inmunoterapia y la terapia antiangiogénica, validando los esfuerzos de Galtec, la empresa biotecnológica que Rabinovich fundó en 2023 con apoyo público y privado, enfocada en llevar estos descubrimientos a tratamientos concretos para pacientes.
Nacido en Villa Cabrera, Córdoba, en 1969, Rabinovich se sintió atraído por la biología y la química desde joven, incluso ayudando en la farmacia de sus padres. Su pasión por la inmunología lo llevó a descubrir la galectina-1 en el sistema inmune humano por casualidad, un hallazgo que se convirtió en el eje de su tesis doctoral y de tres décadas de investigación. La motivación para su trabajo se intensificó cuando el cáncer afectó a personas cercanas, impulsándolo a buscar estrategias para bloquear la GAL1 y asegurar que la tecnología desarrollada llegue a la gente.
Rabinovich, reconocido como investigador y miembro de academias científicas en América, Europa y Asia, describe a la galectina-1 como una molécula con “dos caras”: puede suprimir la inmunidad para favorecer tumores, pero también proteger en enfermedades inflamatorias. Su compromiso no es solo con la ciencia en Argentina, sino con ofrecer nuevos conocimientos al mundo, impulsado por la curiosidad diaria y el deseo de que sus tecnologías no se pierdan, sino que lleguen a “cada rincón de la Argentina, de Latinoamérica y del mundo”.
